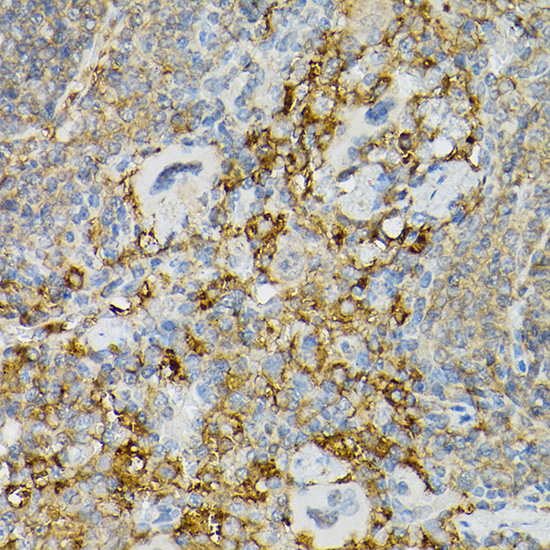
产品细节图片4
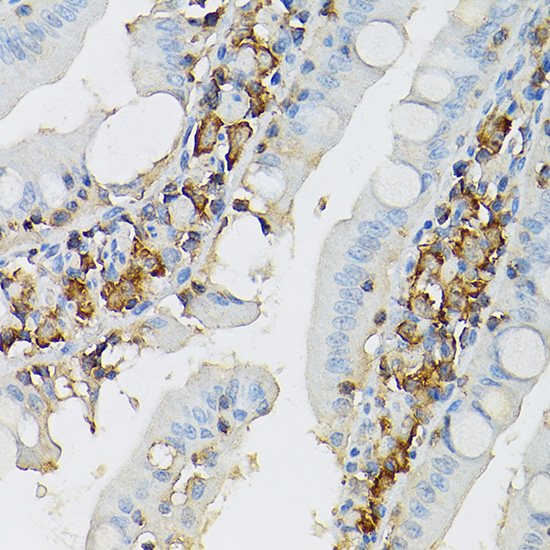
产品细节图片6

相关产品推荐更多 >
万千商家帮你免费找货
0 人在求购买到急需产品
- 详细信息
- 文献和实验
- 技术资料
- 免疫原:
Recombinant fusion protein of human CD117/c-Kit (NP_000213.1).
- 形态:
liquid
- 保存条件:
Store at -20˚C
- 克隆性:
Polyclonal
- 适应物种:
Human;Mouse;Rat
- 保质期:
12 months
- 抗原来源:
Rabbit
- 供应商:
南京赛戈巍生物科技有限公司
- 宿主:
Rabbit
- 应用范围:
WB,IHC,IF
- 靶点:
Uniprot:P10721
- 抗体英文名:
KIT Rabbit Polyclonal Antibody
- 规格:
50ul/100ul
计算分子量:46kDa/109kDa
配方:PBS with 0.02% sodium azide,50% glycerol,pH7.3.
应用详情:WB 1:500 - 1:2000
IHC 1:50 - 1:200
IF 1:50 - 1:200
图片:

Western blot analysis of extracts of various cell lines, using CD117/c-Kit antibody.
,

Immunohistochemistry of paraffin-embedded human gastric cancer using CD117/c-Kit antibody.
,

Immunohistochemistry of paraffin-embedded mouse intestin using CD117/c-Kit antibody.
,
Immunohistochemistry of paraffin-embedded mouse spleen using CD117/c-Kit antibody.
,

Immunohistochemistry of paraffin-embedded rat kidney using CD117/c-Kit antibody.
,
Immunohistochemistry of paraffin-embedded rat intestine using CD117/c-Kit antibody.
,

Immunofluorescence analysis of NIH/3T3 cells using CD117/c-Kit antibody.
,

Immunofluorescence analysis of PC-12 cells using CD117/c-Kit antibody.
风险提示:丁香通仅作为第三方平台,为商家信息发布提供平台空间。用户咨询产品时请注意保护个人信息及财产安全,合理判断,谨慎选购商品,商家和用户对交易行为负责。对于医疗器械类产品,请先查证核实企业经营资质和医疗器械产品注册证情况。
 文献和实验
文献和实验Polyclonal Antibody Production
Zealand White Rabbits and have them delivered to the ARC. Don’t put all your eggs in one basket only using one rabbit. Let them get accustomed to there home there for two weeks before the first pre-bleed. Pre-bleed
Polyclonal Antibody Production
Polyclonal Antibody Production Very useful for rapid and simple generation of antibodies for western blots, ELISA assays, and immunoprecipitation. Rabbit Immunization Initial Preparation Your antigen
Generation and Selection of Rabbit Antibody Libraries by Phage Display
The rabbit antibody repertoire is an exceptional source for both polyclonal antibodies (pAbs) and monoclonal antibodies (mAbs) that combine high specificity with high avidity and affinity, respectively. In contrast to rabbit pAbs
 技术资料
技术资料暂无技术资料 索取技术资料





![Mouse Anti-Duck IgY (H&L) - AF633[L35429]](https://img1.dxycdn.com/p/s14/2025/0922/498/0460884283108299691.jpg!wh200)
![LAIR1 Conjugated Antibody[C35800]](https://img1.dxycdn.com/p/s14/2025/0923/278/4431488150116040791.jpg!wh200)

